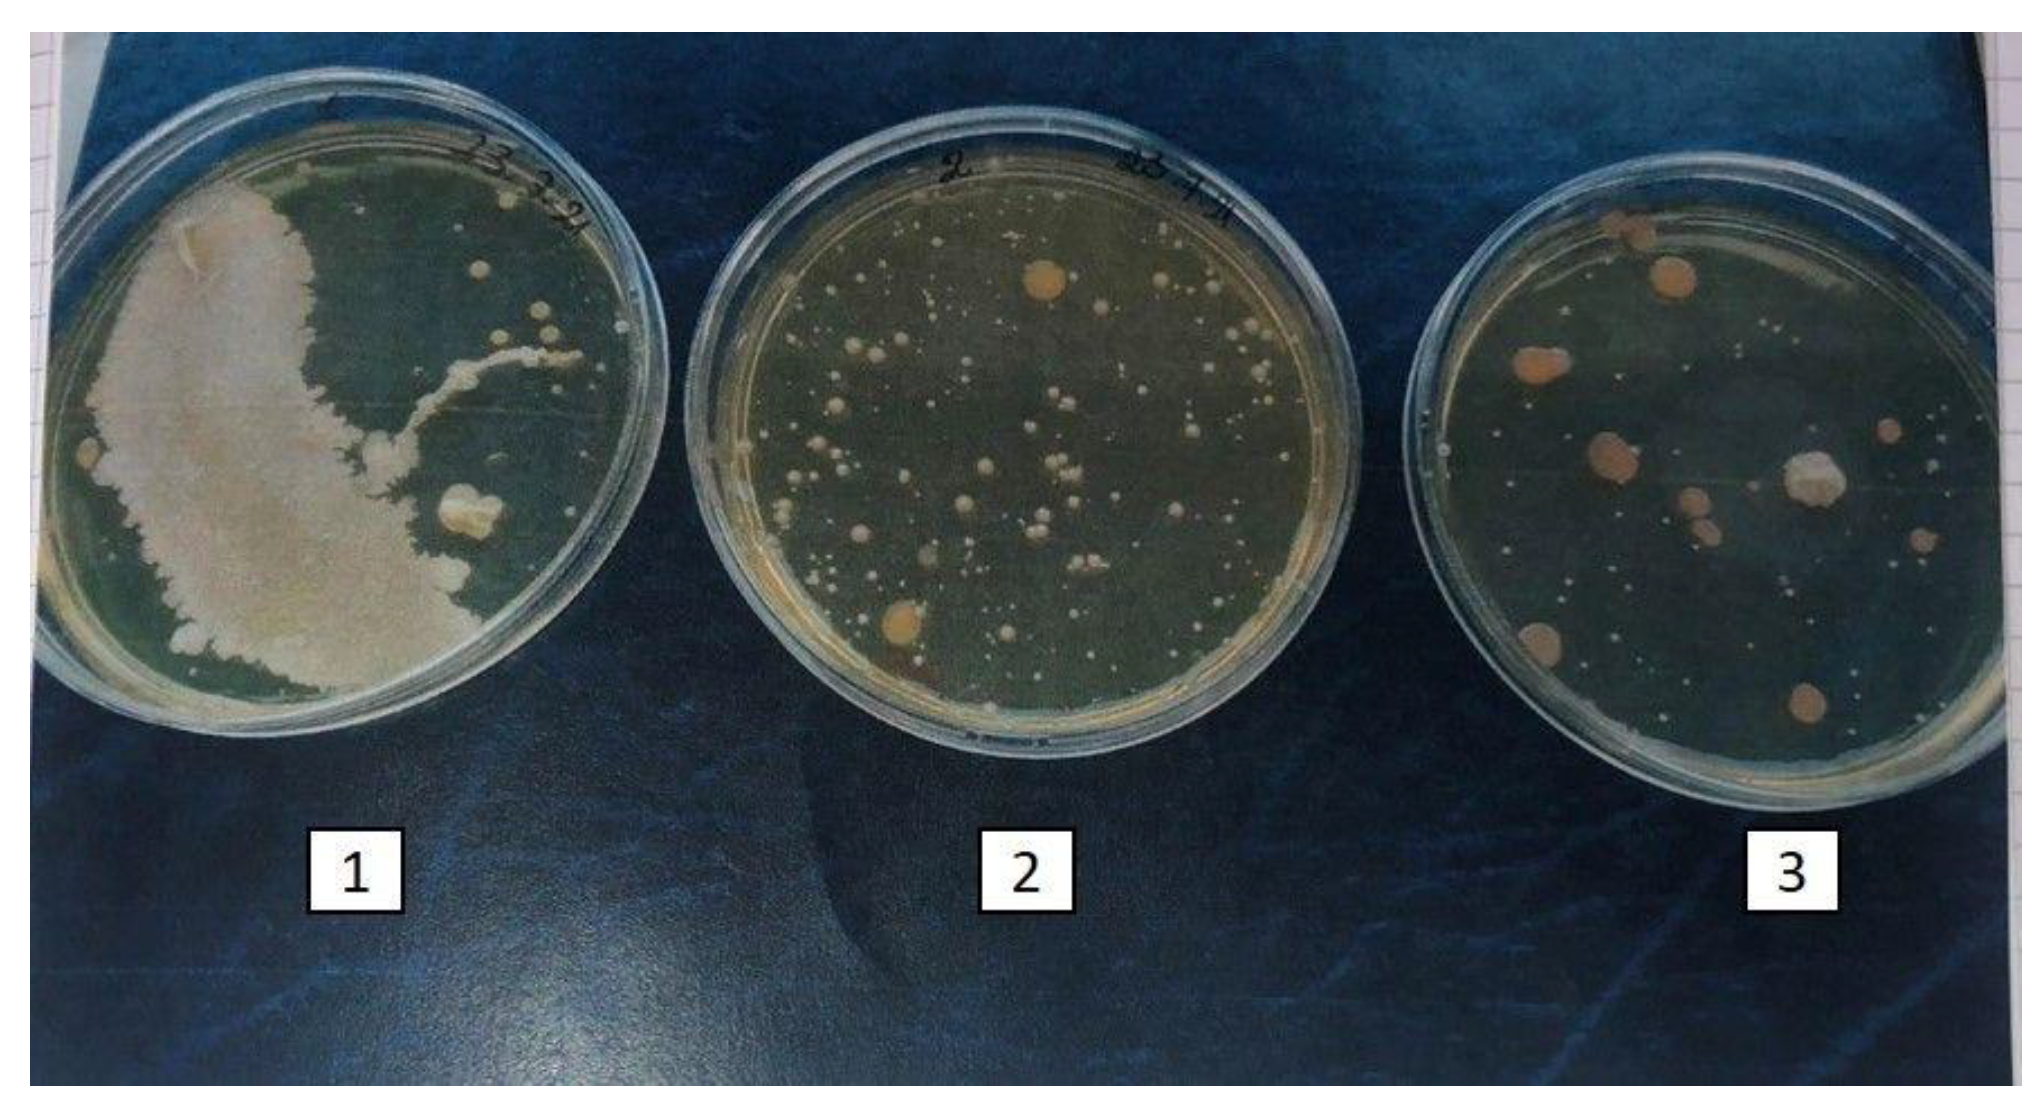
Ijms 23 02600 g004

Exploitation of the Antibacterial Properties of Photoactivated Curcumin as ‘Green’ Tool for Food Preservation
Abstract
1. Introduction
2. Principal Microbial Contaminant of Food
3. Curcumin: Chemical Characterization
4. Mechanisms of Antimicrobial Action of Curcumin
5. Enhancement of Curcumin Antimicrobial Effects by Photoactivation
6. Further Considerations on Food Treatment
7. Photoactivated Curcumin as ‘Green’ Tool for Food Preservation: Future Perspective
Author Contributions
Funding
Institutional Review Board Statement
Informed Consent Statement
Data Availability Statement
Conflicts of Interest
References
- Yoon, J.-H.; Lee, S.-Y. Review: Comparison of the Effectiveness of Decontaminating Strategies for Fresh Fruits and Vegetables and Related Limitations. Crit. Rev. Food Sci. Nutr. 2018, 58, 3189–3208. [Google Scholar] [CrossRef] [PubMed]
- Sridhar, A.; Ponnuchamy, M.; Kumar, P.S.; Kapoor, A. Food Preservation Techniques and Nanotechnology for Increased Shelf Life of Fruits, Vegetables, Beverages and Spices: A Review. Environ. Chem. Lett. 2021, 19, 1715–1735. [Google Scholar] [CrossRef] [PubMed]
- Deng, L.-Z.; Mujumdar, A.S.; Pan, Z.; Vidyarthi, S.K.; Xu, J.; Zielinska, M.; Xiao, H.-W. Emerging Chemical and Physical Disinfection Technologies of Fruits and Vegetables: A Comprehensive Review. Crit. Rev. Food Sci. Nutr. 2020, 60, 2481–2508. [Google Scholar] [CrossRef]
- Cossu, M.; Ledda, L.; Cossu, A. Emerging Trends in the Photodynamic Inactivation (PDI) Applied to the Food Decontamination. Food Res. Int. 2021, 144, 110358. [Google Scholar] [CrossRef]
- Wang, Y.; Wang, Y.; Wang, Y.; Murray, C.K.; Hamblin, M.R.; Hooper, D.C.; Dai, T. Antimicrobial Blue Light Inactivation of Pathogenic Microbes: State of the Art. Drug Resist. Updates 2017, 33–35, 1–22. [Google Scholar] [CrossRef] [PubMed]
- Hamblin, M.R. Antimicrobial Photodynamic Inactivation: A Bright New Technique to Kill Resistant Microbes. Curr. Opin. Microbiol. 2016, 33, 67–73. [Google Scholar] [CrossRef]
- Seidi Damyeh, M.; Mereddy, R.; Netzel, M.E.; Sultanbawa, Y. An Insight into Curcumin-Based Photosensitization as a Promising and Green Food Preservation Technology. Compr. Rev. Food Sci. Food Saf. 2020, 19, 1727–1759. [Google Scholar] [CrossRef]
- Alizadeh, N.; Malakzadeh, S. Antioxidant, Antibacterial and Anti-Cancer Activities of β-and γ-CDs/Curcumin Loaded in Chitosan Nanoparticles. Int. J. Biol. Macromol. 2020, 147, 778–791. [Google Scholar] [CrossRef]
- Zorofchian Moghadamtousi, S.; Abdul Kadir, H.; Hassandarvish, P.; Tajik, H.; Abubakar, S.; Zandi, K. A Review on Antibacterial, Antiviral, and Antifungal Activity of Curcumin. Biomed. Res. Int. 2014, 2014, e186864. [Google Scholar] [CrossRef]
- Corrêa, T.Q.; Blanco, K.C.; Garcia, É.B.; Perez, S.M.L.; Chianfrone, D.J.; Morais, V.S.; Bagnato, V.S. Effects of Ultraviolet Light and Curcumin-Mediated Photodynamic Inactivation on Microbiological Food Safety: A Study in Meat and Fruit. Photodiagnosis Photodyn. Ther. 2020, 30, 101678. [Google Scholar] [CrossRef]
- Martinović, T.; Andjelković, U.; Gajdošik, M.Š.; Rešetar, D.; Josić, D. Foodborne Pathogens and Their Toxins. J. Proteom. 2016, 147, 226–235. [Google Scholar] [CrossRef] [PubMed]
- Lim, J.Y.; Yoon, J.; Hovde, C.J. A Brief Overview of Escherichia Coli O157:H7 and Its Plasmid O157. J. Microbiol. Biotechnol. 2010, 20, 5–14. [Google Scholar] [CrossRef] [PubMed]
- Anderson, A.C.; Jonas, D.; Huber, I.; Karygianni, L.; Wölber, J.; Hellwig, E.; Arweiler, N.; Vach, K.; Wittmer, A.; Al-Ahmad, A. Enterococcus Faecalis from Food, Clinical Specimens, and Oral Sites: Prevalence of Virulence Factors in Association with Biofilm Formation. Front. Microbiol. 2016, 6, 1534. [Google Scholar] [CrossRef]
- Tolker-Nielsen, T. Biofilm Development. Microbiol. Spectr. 2015, 3, 2. [Google Scholar] [CrossRef] [PubMed]
- Jamet, E.; Akary, E.; Poisson, M.-A.; Chamba, J.-F.; Bertrand, X.; Serror, P. Prevalence and Characterization of Antibiotic Resistant Enterococcus Faecalis in French Cheeses. Food Microbiol. 2012, 31, 191–198. [Google Scholar] [CrossRef] [PubMed]
- Kadariya, J.; Smith, T.C.; Thapaliya, D. Staphylococcus Aureus and Staphylococcal Food-Borne Disease: An Ongoing Challenge in Public Health. Biomed. Res. Int. 2014, 2014, e827965. [Google Scholar] [CrossRef] [PubMed]
- Argudín, M.Á.; Mendoza, M.C.; Rodicio, M.R. Food Poisoning and Staphylococcus Aureus Enterotoxins. Toxins 2010, 2, 1751–1773. [Google Scholar] [CrossRef]
- Jia, K.; Fang, T.; Wang, X.; Liu, Y.; Sun, W.; Wang, Y.; Ding, T.; Wang, J.; Li, C.; Xu, D.; et al. Antibiotic Resistance Patterns of Staphylococcus Aureus Isolates from Retail Foods in Mainland China: A Meta-Analysis. Foodborne Pathog. Dis. 2020, 17, 296–307. [Google Scholar] [CrossRef]
- Chajęcka-Wierzchowska, W.; Zadernowska, A.; Łaniewska-Trokenheim, Ł. Staphylococcus aureus from ready-to-eat food as a source of multiple antibiotic resistance genes. Cbu Int. Conf. Proc. 2017, 5, 1108–1112. [Google Scholar] [CrossRef][Green Version]
- Pormohammad, A.; Nasiri, M.J.; Azimi, T. Prevalence of antibiotic resistance in Escherichia coli strains simultaneously isolated from humans, animals, food, and the environment: A systematic review and meta-analysis. IDR 2019, 12, 1181–1197. [Google Scholar] [CrossRef]
- Barlaam, A.; Parisi, A.; Spinelli, E.; Caruso, M.; Taranto, P.D.; Normanno, G. global Emergence of Colistin-Resistant Escherichia Coli in Food Chains and Associated Food Safety Implications: A Review. J. Food Prot. 2019, 82, 1440–1448. [Google Scholar] [CrossRef] [PubMed]
- Pawlowska, A.M.; Zannini, E.; Coffey, A.; Arendt, E.K. Chapter 5—“Green Preservatives”: Combating Fungi in the Food and Feed Industry by Applying Antifungal Lactic Acid Bacteria. In Advances in Food and Nutrition Research; Henry, J., Ed.; Academic Press: Cambridge, MA, USA, 2012; Volume 66, pp. 217–238. [Google Scholar]
- Pietsch, C.; Müller, G.; Mourabit, S.; Carnal, S.; Bandara, K. Occurrence of Fungi and Fungal Toxins in Fish Feed during Storage. Toxins 2020, 12, 171. [Google Scholar] [CrossRef]
- Singh, B.K.; Tiwari, S.; Dubey, N.K. Essential Oils and Their Nanoformulations as Green Preservatives to Boost Food Safety against Mycotoxin Contamination of Food Commodities: A Review. J. Sci. Food Agric. 2021, 101, 4879–4890. [Google Scholar] [CrossRef] [PubMed]
- Gil-Serna, J.; García-Díaz, M.; Vázquez, C.; González-Jaén, M.T.; Patiño, B. Significance of Aspergillus Niger Aggregate Species as Contaminants of Food Products in Spain Regarding Their Occurrence and Their Ability to Produce Mycotoxins. Food Microbiol. 2019, 82, 240–248. [Google Scholar] [CrossRef] [PubMed]
- Luo, S.; Du, H.; Kebede, H.; Liu, Y.; Xing, F. Contamination Status of Major Mycotoxins in Agricultural Product and Food Stuff in Europe. Food Control. 2021, 127, 108120. [Google Scholar] [CrossRef]
- Thanushree, M.P.; Sailendri, D.; Yoha, K.S.; Moses, J.A.; Anandharamakrishnan, C. Mycotoxin Contamination in Food: An Exposition on Spices. Trends Food Sci. Technol. 2019, 93, 69–80. [Google Scholar] [CrossRef]
- Liu, Y.; Galani Yamdeu, J.H.; Gong, Y.Y.; Orfila, C. A Review of Postharvest Approaches to Reduce Fungal and Mycotoxin Contamination of Foods. Compr. Rev. Food Sci. Food Saf. 2020, 19, 1521–1560. [Google Scholar] [CrossRef] [PubMed]
- Yeargin, T.; Gibson, K.e. Key Characteristics of Foods with an Elevated Risk for Viral Enteropathogen Contamination. J. Appl. Microbiol. 2019, 126, 996–1010. [Google Scholar] [CrossRef]
- Shukla, S.; Cho, H.; Kwon, O.J.; Chung, S.H.; Kim, M. Prevalence and Evaluation Strategies for Viral Contamination in Food Products: Risk to Human Health—A Review. Crit. Rev. Food Sci. Nutr. 2018, 58, 405–419. [Google Scholar] [CrossRef]
- Thakali, A.; MacRae, J.D. A Review of Chemical and Microbial Contamination in Food: What Are the Threats to a Circular Food System? Environ. Res. 2021, 194, 110635. [Google Scholar] [CrossRef]
- Tyagi, P.; Singh, M.; Kumari, H.; Kumari, A.; Mukhopadhyay, K. Bactericidal Activity of Curcumin I Is Associated with Damaging of Bacterial Membrane. PLoS ONE 2015, 10, e0121313. [Google Scholar] [CrossRef] [PubMed]
- Payton, F.; Sandusky, P.; Alworth, W.L. NMR Study of the Solution Structure of Curcumin. J. Nat. Prod. 2007, 70, 143–146. [Google Scholar] [CrossRef] [PubMed]
- Heger, M.; van Golen, R.F.; Broekgaarden, M.; Michel, M.C. The Molecular Basis for the Pharmacokinetics and Pharmacodynamics of Curcumin and Its Metabolites in Relation to Cancer. Pharm. Rev. 2014, 66, 222–307. [Google Scholar] [CrossRef] [PubMed]
- Menon, V.P.; Sudheer, A.R. Antioxidant and anti-inflammatory properties of curcumin. In The Molecular Targets and Therapeutic Uses of Curcumin in Health and Disease; Aggarwal, B.B., Surh, Y.-J., Shishodia, S., Eds.; Advances in experimental medicine and biology; Springer: Boston, MA, USA, 2007; pp. 105–125. ISBN 978-0-387-46401-5. [Google Scholar]
- Anand, P.; Kunnumakkara, A.B.; Newman, R.A.; Aggarwal, B.B. Bioavailability of Curcumin: Problems and Promises. Mol. Pharm. 2007, 4, 807–818. [Google Scholar] [CrossRef]
- Shoba, G.; Joy, D.; Joseph, T.; Majeed, M.; Rajendran, R.; Srinivas, P.S.S.R. Influence of Piperine on the Pharmacokinetics of Curcumin in Animals and Human Volunteers. Planta Med. 1998, 64, 353–356. [Google Scholar] [CrossRef]
- Bergonzi, M.C.; Hamdouch, R.; Mazzacuva, F.; Isacchi, B.; Bilia, A.R. Optimization, Characterization and in Vitro Evaluation of Curcumin Microemulsions. Lwt Food Sci. Technol. 2014, 59, 148–155. [Google Scholar] [CrossRef]
- Joung, H.J.; Choi, M.-J.; Kim, J.T.; Park, S.H.; Park, H.J.; Shin, G.H. Development of Food-Grade Curcumin Nanoemulsion and Its Potential Application to Food Beverage System: Antioxidant Property and In Vitro Digestion. J. Food Sci. 2016, 81, N745–N753. [Google Scholar] [CrossRef] [PubMed]
- Negi, P.S.; Jayaprakasha, G.K.; Jagan Mohan Rao, L.; Sakariah, K.K. Antibacterial Activity of Turmeric Oil: A Byproduct from Curcumin Manufacture. J. Agric. Food Chem. 1999, 47, 4297–4300. [Google Scholar] [CrossRef]
- Mun, S.-H.; Joung, D.-K.; Kim, Y.-S.; Kang, O.-H.; Kim, S.-B.; Seo, Y.-S.; Kim, Y.-C.; Lee, D.-S.; Shin, D.-W.; Kweon, K.-T.; et al. Synergistic Antibacterial Effect of Curcumin against Methicillin-Resistant Staphylococcus Aureus. Phytomed. Int. J. Phytother. Phytopharm. 2013, 20, 714–718. [Google Scholar] [CrossRef]
- Rai, D.; Singh, J.K.; Roy, N.; Panda, D. Curcumin Inhibits FtsZ Assembly: An Attractive Mechanism for Its Antibacterial Activity. Biochem. J. 2008, 410, 147–155. [Google Scholar] [CrossRef]
- Rudrappa, T.; Bais, H.P. Curcumin, a Known Phenolic from Curcuma Longa, Attenuates the Virulence of Pseudomonas Aeruginosa PAO1 in Whole Plant and Animal Pathogenicity Models. J. Agric. Food Chem. 2008, 56, 1955–1962. [Google Scholar] [CrossRef] [PubMed]
- Shlar, I.; Droby, S.; Choudhary, R.; Rodov, V. The Mode of Antimicrobial Action of Curcumin Depends on the Delivery System: Monolithic Nanoparticles vs. Supramolecular Inclusion Complex. Rsc Adv. 2017, 7, 42559–42569. [Google Scholar] [CrossRef]
- Rajagopal, M.; Walker, S. Envelope Structures of Gram-Positive Bacteria. In Protein and Sugar Export and Assembly in Gram-Positive Bacteria; Bagnoli, F., Rappuoli, R., Eds.; Current Topics in Microbiology and Immunology; Springer International Publishing: Cham, Switzerland, 2017; pp. 1–44. ISBN 978-3-319-56014-4. [Google Scholar]
- Mun, S.-H.; Kim, S.-B.; Kong, R.; Choi, J.-G.; Kim, Y.-C.; Shin, D.-W.; Kang, O.-H.; Kwon, D.-Y. Curcumin Reverse Methicillin Resistance in Staphylococcus Aureus. Molecules 2014, 19, 18283–18295. [Google Scholar] [CrossRef] [PubMed]
- Reddy, P.J.; Sinha, S.; Ray, S.; Sathe, G.J.; Chatterjee, A.; Prasad, T.S.K.; Dhali, S.; Srikanth, R.; Panda, D.; Srivastava, S. Comprehensive Analysis of Temporal Alterations in Cellular Proteome of Bacillus Subtilis under Curcumin Treatment. PLoS ONE 2015, 10, e0120620. [Google Scholar] [CrossRef]
- Yun, D.G.; Lee, D.G. Antibacterial Activity of Curcumin via Apoptosis-like Response in Escherichia coli. Appl. Microbiol. Biotechnol. 2016, 100, 5505–5514. [Google Scholar] [CrossRef]
- Hawver, L.A.; Jung, S.A.; Ng, W.-L. Specificity and Complexity in Bacterial Quorum-Sensing Systems. Fems Microbiol. Rev. 2016, 40, 738–752. [Google Scholar] [CrossRef]
- Zheng, D.; Huang, C.; Huang, H.; Zhao, Y.; Khan, M.R.U.; Zhao, H.; Huang, L. Antibacterial Mechanism of Curcumin: A Review. Chem. Biodiv. 2020, 17, e2000171. [Google Scholar] [CrossRef]
- Kievit, T.R.D.; Gillis, R.; Marx, S.; Brown, C.; Iglewski, B.H. Quorum-Sensing Genes in Pseudomonas Aeruginosa Biofilms: Their Role and Expression Patterns. Appl. Environ. Microbiol. 2001, 67, 1865–1873. [Google Scholar] [CrossRef]
- Kübler, A.C. Photodynamic Therapy. Med Laser Appl. 2005, 20, 37–45. [Google Scholar] [CrossRef]
- Aurum, F.S.; Nguyen, L.T. Efficacy of Photoactivated Curcumin to Decontaminate Food Surfaces under Blue Light Emitting Diode. J. Food Process. Eng. 2019, 42, e12988. [Google Scholar] [CrossRef]
- Mondal, S.; Ghosh, S.; Moulik, S.P. Stability of Curcumin in Different Solvent and Solution Media: UV-Visible and Steady-State Fluorescence Spectral Study. J. Photochem. Photobiol. BBiol. 2016, 158, 212–218. [Google Scholar] [CrossRef] [PubMed]
- Gonzales, J.C.; Brancini, G.T.P.; Rodrigues, G.B.; Silva-Junior, G.J.; Bachmann, L.; Wainwright, M.; Braga, G.Ú.L. Photodynamic Inactivation of Conidia of the Fungus Colletotrichum Abscissum on Citrus Sinensis Plants with Methylene Blue under Solar Radiation. J. Photochem. Photobiol. B Biol. 2017, 176, 54–61. [Google Scholar] [CrossRef] [PubMed]
- Majiya, H.; Galstyan, A. Dye Extract of Calyces of Hibiscus Sabdariffa Has Photodynamic Antibacterial Activity: A Prospect for Sunlight-Driven Fresh Produce Sanitation. Food Sci. Nutr. 2020, 8, 3200–3211. [Google Scholar] [CrossRef] [PubMed]
- Ghate, V.; Leong, A.L.; Kumar, A.; Bang, W.S.; Zhou, W.; Yuk, H.-G. Enhancing the Antibacterial Effect of 461 and 521 Nm Light Emitting Diodes on Selected Foodborne Pathogens in Trypticase Soy Broth by Acidic and Alkaline PH Conditions. Food Microbiol. 2015, 48, 49–57. [Google Scholar] [CrossRef] [PubMed]
- Kim, M.-J.; Yuk, H.-G. Antibacterial Mechanism of 405-Nanometer Light-Emitting Diode against Salmonella at Refrigeration Temperature. Appl. Environ. Microbiol. 2016, 83, e02582-16. [Google Scholar] [CrossRef]
- Huang, J.; Chen, B.; Li, H.; Zeng, Q.-H.; Wang, J.J.; Liu, H.; Pan, Y.; Zhao, Y. Enhanced Antibacterial and Antibiofilm Functions of the Curcumin-Mediated Photodynamic Inactivation against Listeria Monocytogenes. Food Control. 2020, 108, 106886. [Google Scholar] [CrossRef]
- Montllor-Albalate, C.; Colin, A.E.; Chandrasekharan, B.; Bolaji, N.; Andersen, J.L.; Wayne Outten, F.; Reddi, A.R. Extra-Mitochondrial Cu/Zn Superoxide Dismutase (Sod1) Is Dispensable for Protection against Oxidative Stress but Mediates Peroxide Signaling in Saccharomyces Cerevisiae. Redox Biol. 2019, 21, 101064. [Google Scholar] [CrossRef]
- Endarko, E.; MacLean, M.; Timoshkin, I.; MacGregor, S.; Anderson, J. High-Intensity 405 Nm Light Inactivation of Listeria Monocytogenes. Photochem. Photobiol. 2012, 88, 1280–1286. [Google Scholar] [CrossRef]
- Munir, Z.; Cavallo, L.; Menotti, F.; Tullio, V.; Comini, S.; Cavalli, R.; Guiot, C.; Cuffini, A.M.; Banche, G.; Mandras, N. Evaluation of Chitosan/Curcumin loaded Nanobubbles with and without Photoactivated light for Food Preservation. Poster Communication for Società Italiana di Microbiologia 2021, Virtual Congress, 16–17 and 20–21 September 2021. [Google Scholar]
- Munir, Z.; Cavalli, R.; Banche, G.; Mandras, N.; Guiot, C. Application of Curcumin-Loaded Nanobubbles with and without Photodynamic Light (LED) for Food Preservation. Poster Communication for Nanoinnovation 2021, Rome, Italy, 21–24 September 2021. [Google Scholar]
- Penha, C.B.; Bonin, E.; da Silva, A.F.; Hioka, N.; Zanqueta, É.B.; Nakamura, T.U.; de Abreu Filho, B.A.; Campanerut-Sá, P.A.Z.; Mikcha, J.M.G. Photodynamic Inactivation of Foodborne and Food Spoilage Bacteria by Curcumin. Lwt Food Sci. Technol. 2017, 76, 198–202. [Google Scholar] [CrossRef]
- Jiang, Y.; Liang, Y.; Zhang, H.; Zhang, W.; Tu, S. Preparation and Biocompatibility of Grafted Functional β-Cyclodextrin Copolymers from the Surface of PET Films. Mater. Sci. Eng. C 2014, 41, 1–7. [Google Scholar] [CrossRef] [PubMed]
- Costa, L.; Tomé, J.P.C.; Neves, M.G.; Tomé, A.C.; Cavaleiro, J.A.S.; Faustino, M.A.F.; Cunha, Â.; Gomes, N.C.M.; Almeida, A. Evaluation of Resistance Development and Viability Recovery by a Non-Enveloped Virus after Repeated Cycles of APDT. Antivir. Res. 2011, 91, 278–282. [Google Scholar] [CrossRef] [PubMed]
- Neelakantan, P.; Cheng, C.Q.; Ravichandran, V.; Mao, T.; Sriraman, P.; Sridharan, S.; Subbarao, C.; Sharma, S.; Kishen, A. Photoactivation of Curcumin and Sodium Hypochlorite to Enhance Antibiofilm Efficacy in Root Canal Dentin. Photodiagnosis Photodyn. Ther. 2015, 12, 108–114. [Google Scholar] [CrossRef] [PubMed]
- Zou, Y.; Yu, Y.; Cheng, L.; Li, L.; Zou, B.; Wu, J.; Zhou, W.; Li, J.; Xu, Y. Effects of Curcumin-Based Photodynamic Treatment on Quality Attributes of Fresh-Cut Pineapple. LWT 2021, 141, 110902. [Google Scholar] [CrossRef]
- Wu, J.; Hou, W.; Cao, B.; Zuo, T.; Xue, C.; Leung, A.W.; Xu, C.; Tang, Q.-J. Virucidal Efficacy of Treatment with Photodynamically Activated Curcumin on Murine Norovirus Bio-Accumulated in Oysters. Photodiagnosis Photodyn. Ther. 2015, 12, 385–392. [Google Scholar] [CrossRef]
- Liu, F.; Li, Z.; Cao, B.; Wu, J.; Wang, Y.; Xue, Y.; Xu, J.; Xue, C.; Tang, Q.J. The Effect of a Novel Photodynamic Activation Method Mediated by Curcumin on Oyster Shelf Life and Quality. Food Res. Int. 2016, 87, 204–210. [Google Scholar] [CrossRef] [PubMed]
- Chen, B.; Huang, J.; Li, H.; Zeng, Q.-H.; Wang, J.J.; Liu, H.; Pan, Y.; Zhao, Y. Eradication of Planktonic Vibrio Parahaemolyticus and Its Sessile Biofilm by Curcumin-Mediated Photodynamic Inactivation. Food Control. 2020, 113, 107181. [Google Scholar] [CrossRef]
- Al-Asmari, F.; Mereddy, R.; Sultanbawa, Y. The Effect of Photosensitization Mediated by Curcumin on Storage Life of Fresh Date (Phoenix Dactylifera L.) Fruit. Food Control. 2018, 93, 305–309. [Google Scholar] [CrossRef]
- Song, L.; Zhang, F.; Yu, J.; Wei, C.; Han, Q.; Meng, X. Antifungal Effect and Possible Mechanism of Curcumin Mediated Photodynamic Technology against Penicillium Expansum. Postharvest Biol. Technol. 2020, 167, 111234. [Google Scholar] [CrossRef]
- Schamberger, B.; Plaetzer, K. Photofungizides Based on Curcumin and Derivates Thereof against Candida Albicans and Aspergillus Niger. Antibiotics 2021, 10, 1315. [Google Scholar] [CrossRef]
- Nguenha, R.J.; Damyeh, M.S.; Hong, H.T.; Chaliha, M.; Sultanbawa, Y. Effect of Solvents on Curcumin as a Photosensitizer and Its Ability to Inactivate Aspergillus Flavus and Reduce Aflatoxin B1 in Maize Kernels and Flour. J. Food Process. Preserv. 2022, 46, e16169. [Google Scholar] [CrossRef]
- Randazzo, W.; Aznar, R.; Sánchez, G. Curcumin-Mediated Photodynamic Inactivation of Norovirus Surrogates. Food Environ. Virol. 2016, 8, 244–250. [Google Scholar] [CrossRef] [PubMed]
- Dahl, T.A.; McGowan, W.M.; Shand, M.A.; Srinivasan, V.S. Photokilling of Bacteria by the Natural Dye Curcumin. Arch. Microbiol. 1989, 151, 183–185. [Google Scholar] [CrossRef] [PubMed]
- de Oliveira, E.F.; Tosati, J.V.; Tikekar, R.V.; Monteiro, A.R.; Nitin, N. Antimicrobial Activity of Curcumin in Combination with Light against Escherichia Coli O157:H7 and Listeria Innocua: Applications for Fresh Produce Sanitation. Postharvest Biol. Technol. 2018, 137, 86–94. [Google Scholar] [CrossRef]
- Maisch, T.; Szeimies, R.-M.; Jori, G.; Abels, C. Antibacterial Photodynamic Therapy in Dermatology. Photochem. Photobiol. Sci. 2004, 3, 907–917. [Google Scholar] [CrossRef] [PubMed]
- Agel, M.R.; Baghdan, E.; Pinnapireddy, S.R.; Lehmann, J.; Schäfer, J.; Bakowsky, U. Curcumin Loaded Nanoparticles as Efficient Photoactive Formulations against Gram-Positive and Gram-Negative Bacteria. Colloids Surf. B Biointerfaces 2019, 178, 460–468. [Google Scholar] [CrossRef]
- Ryu, V.; Ruiz-Ramirez, S.; Chuesiang, P.; McLandsborough, L.A.; McClements, D.J.; Corradini, M.G. Use of Micellar Delivery Systems to Enhance Curcumin’s Stability and Microbial Photoinactivation Capacity. Foods 2021, 10, 1777. [Google Scholar] [CrossRef]

| Bacteria | Gram | Contaminate Food | Health Damage Mechanism | Antibiotic Resistance |
|---|---|---|---|---|
| E. faecalis | + | Cheeses, fermented sausages, andready-to-eat food. | Enterococcal surface proteins, hyaluronidase, gelatinase, and biofilm production [14]. | The most prevalent antibiotic resistances were found to be tetracycline, minocycline, erythromycin kanamycin, and chloramphenicol [15]. |
| S. aureus | + | Fruits, meat, egg products, milk and its derivatives, salads, and baked goods such as pastries and cream-filled desserts. | Staphylococcal enterotoxins (SEs) causing Staphylococcal foodborne disease (SFD) [16,17]. | Foodborne strain methicillin-resistant S. aureus (MRSA) with the highest resistance rate to penicillin G, ampicillin, and erythromycin [18,19]. |
| E. coli (specifically the enterohemorrhagic serogroup O157:H7) | - | Dairy products, delicatessen products, salads, spices, cream cakes, and fresh fruit and vegetables. | Shiga toxins, pathogenicity island products, and F-like plasmid pO157 products. | Colistin had the lowest prevalence (0.8%) and amoxicillin had the highest (70.5%), a recent and significant increase in ciprofloxacin resistance [20,21]. |
| Bacteria | MIC (mg/mL) No LED | MIC (mg/mL) 3 h LED | MBC (mg/mL) No LED | MBC (mg/mL) 3 h LED |
|---|---|---|---|---|
| E. faecalis | 0.125 ± 0.063 | 0.0037 ± 0.0019 | >0.25 | 0.0037 ± 0.0019 |
| S. aureus | 0.06 ± 0.03 | 0.0075 ± 0.063 | >0.25 | 0.0075 ± 0.0038 |
| E.coli | 0.125 ± 0.063 | 0.125 ± 0.063 | >0.25 | >0.25 |
| 1 | 2 | 3 | |
|---|---|---|---|
| Subject | V/O/T/G | V/O/T/G | V/O/T/G |
| A | 1/1/1/1 | 1/1/1/1 | 1/1/1/1 |
| B | 1/1/1/1 | 1/1/1/1 | 1/1/1/1 |
| C | 1/1/1/1 | 1/1/1/1 | 1/1/1/1 |
| D | 1/1/1/1 | 1/1/1/1 | 1/1/1/1 |
Publisher’s Note: MDPI stays neutral with regard to jurisdictional claims in published maps and institutional affiliations. |
© 2022 by the authors. Licensee MDPI, Basel, Switzerland. This article is an open access article distributed under the terms and conditions of the Creative Commons Attribution (CC BY) license (https://creativecommons.org/licenses/by/4.0/).
Share and Cite
Munir, Z.; Banche, G.; Cavallo, L.; Mandras, N.; Roana, J.; Pertusio, R.; Ficiarà, E.; Cavalli, R.; Guiot, C. Exploitation of the Antibacterial Properties of Photoactivated Curcumin as ‘Green’ Tool for Food Preservation. Int. J. Mol. Sci. 2022, 23, 2600. https://doi.org/10.3390/ijms23052600
Munir Z, Banche G, Cavallo L, Mandras N, Roana J, Pertusio R, Ficiarà E, Cavalli R, Guiot C. Exploitation of the Antibacterial Properties of Photoactivated Curcumin as ‘Green’ Tool for Food Preservation. International Journal of Molecular Sciences. 2022; 23(5):2600. https://doi.org/10.3390/ijms23052600
Chicago/Turabian StyleMunir, Zunaira, Giuliana Banche, Lorenza Cavallo, Narcisa Mandras, Janira Roana, Raffaele Pertusio, Eleonora Ficiarà, Roberta Cavalli, and Caterina Guiot. 2022. "Exploitation of the Antibacterial Properties of Photoactivated Curcumin as ‘Green’ Tool for Food Preservation" International Journal of Molecular Sciences 23, no. 5: 2600. https://doi.org/10.3390/ijms23052600
APA StyleMunir, Z., Banche, G., Cavallo, L., Mandras, N., Roana, J., Pertusio, R., Ficiarà, E., Cavalli, R., & Guiot, C. (2022). Exploitation of the Antibacterial Properties of Photoactivated Curcumin as ‘Green’ Tool for Food Preservation. International Journal of Molecular Sciences, 23(5), 2600. https://doi.org/10.3390/ijms23052600

